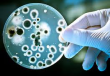

10 Июн 2014
В сообщении газеты The Fresno Bee рассказывается о 39-летней Мелисе Карлтон, проживающей во Фресно (штат Калифорния), которая, будучи беременной, впала в кому...
09 Июн 2014
По сообщению ИТАР-ТАСС, Минздравом РФ планируется создание единого национального иммунологического кластера, который объединит всех существующих сегодня...
05 Дек 2013
Российские ученые совместно с украинскими коллегами пришли к выводу, что причиной образования кальцийфосфатных отложений в организме человека способствуют...
17 Окт 2013
По данным AFP, рак и другие мутации генов появляются из-за растительного экстракта, который содержится в известном снадобье из Китая, помогающем в борьбе с...
08 Сен 2013
Старение организма связано с несколькими белками в гипоталамусе, уверены американские исследователи из Медицинского колледжа в Нью-Йорке.
Как оказалось,...
16 Авг 2013
Применение новых сильнодействующих статинов (таких как розувастатин, симвастатин и аторвастатин) увеличивает риск развития воспаления почек более чем на треть...
05 Июл 2013
Сотрудники Бостонского университета создали соединение, которое может остановить такие смертоносные вирусы как вирус бешенства и вирус Эбола. Против...
12 Июн 2013
Известно, что такое инфекционное заболевание как корь является очень заразным. Им может заразиться человек, посетивший то же помещение, что и больной....
18 Май 2013
Британские медики констатировали, что в течение последнего года на территории Великобритании количество больных неизлечимой формой гонорей выросло на четверть...